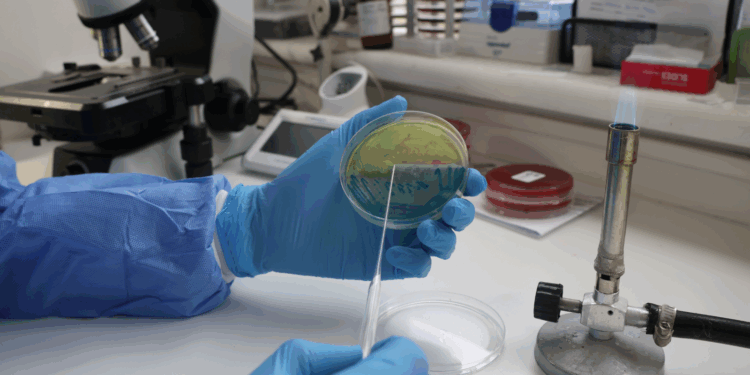
Hospital de Chillán participará en encuesta internacional para combatir la resistencia antimicrobiana

La encuesta Mundial de Punto de Prevalencia, busca recoger datos de hospitales a nivel mundial, sobre el uso de antibióticos y la prevalencia de la resistencia además de la frecuencia de infecciones asociadas a la atención de salud, para ayudar a tomar decisiones en el uso de estos medicamentos. Asimismo, se trabaja en otros estudios regionales con la Universidad del Bío Bío, en la misma temática. El Programa de Optimización de Uso de Antimicrobianos (PROA) del Hospital Clínico Herminda Martín (HCHM), impulsa variadas estrategias académicas para prevenir la resistencia antimicrobiana; producto de las diversas cepas de bacterias resistentes que dificultan el tratamiento de infecciones comunes y aumentan el riesgo de complicaciones más graves. Uno de los estudios es el de Caracterización fenotípica, genómica y clínica de cepas bacterianas multirresistentes en el HCHM: serie de casos, donde también participan como colaboradores, el Laboratorio de Microbiología y la Unidad de Epidemiología e Infectología (UDEI) del Establecimiento. De acuerdo, con el Dr. Cristian Carmona, encargado del equipo PROA del HCHM “el proyecto aprobado por el Comité Ético y Científico, que hacemos en conjunto con la Universidad del Bío Bío, es un estudio que se extenderá por 24 meses (hasta abril de 2027) con un diseño observacional, descriptivo, longitudinal, que busca describir el perfil de resistencia de las bacterias aisladas en nuestro Hospital, secuenciar el genoma de estas cepas, relacionar la información microbiológica con los datos clínicos, para objetivar las bacterias que tienen el mismo genotipo de resistencia, si son las mismas que producen resistencia a nivel veterinario y de la industria alimenticia. A veces hay una relación entre las bacterias que afectan a las personas y las que se ven en contexto agropecuario y veterinario”. En este caso, la información se obtiene de fichas clínicas y muestras procesadas en la
atención habitual, con medidas de confidencialidad. Asimismo, se están preparando para participar en la Encuesta Mundial de Punto de Prevalencia 2025 (Global Point Prevalence Survey) estudio internacional coordinado por la Universidad de Amberes, que en Chile lidera el Ministerio de Salud y el grupo colaborativo de la resistencia bacteriana de la Sociedad Chilena de Infectología. Al respecto, el Dr. Carmona comentó que “es un estudio puntual, que en un mismo día y a nivel mundial permite medir el uso de antibióticos en pacientes hospitalizados, la
prevalencia de la resistencia bacteriana y la frecuencia de infecciones asociadas a la atención en salud. Nuestra participación, nos permitirá obtener un informe propio, que se podrá comparar con datos nacionales, regionales y mundiales, fortaleciendo de esta forma la toma de decisiones, en el uso racional de antimicrobianos y prevención de infecciones, para combatir la resistencia a estos medicamentos y sus consecuencias en los entornos sanitarios”. Cabe destacar, que la recolección de los datos, se realizará en diciembre de este 2025.